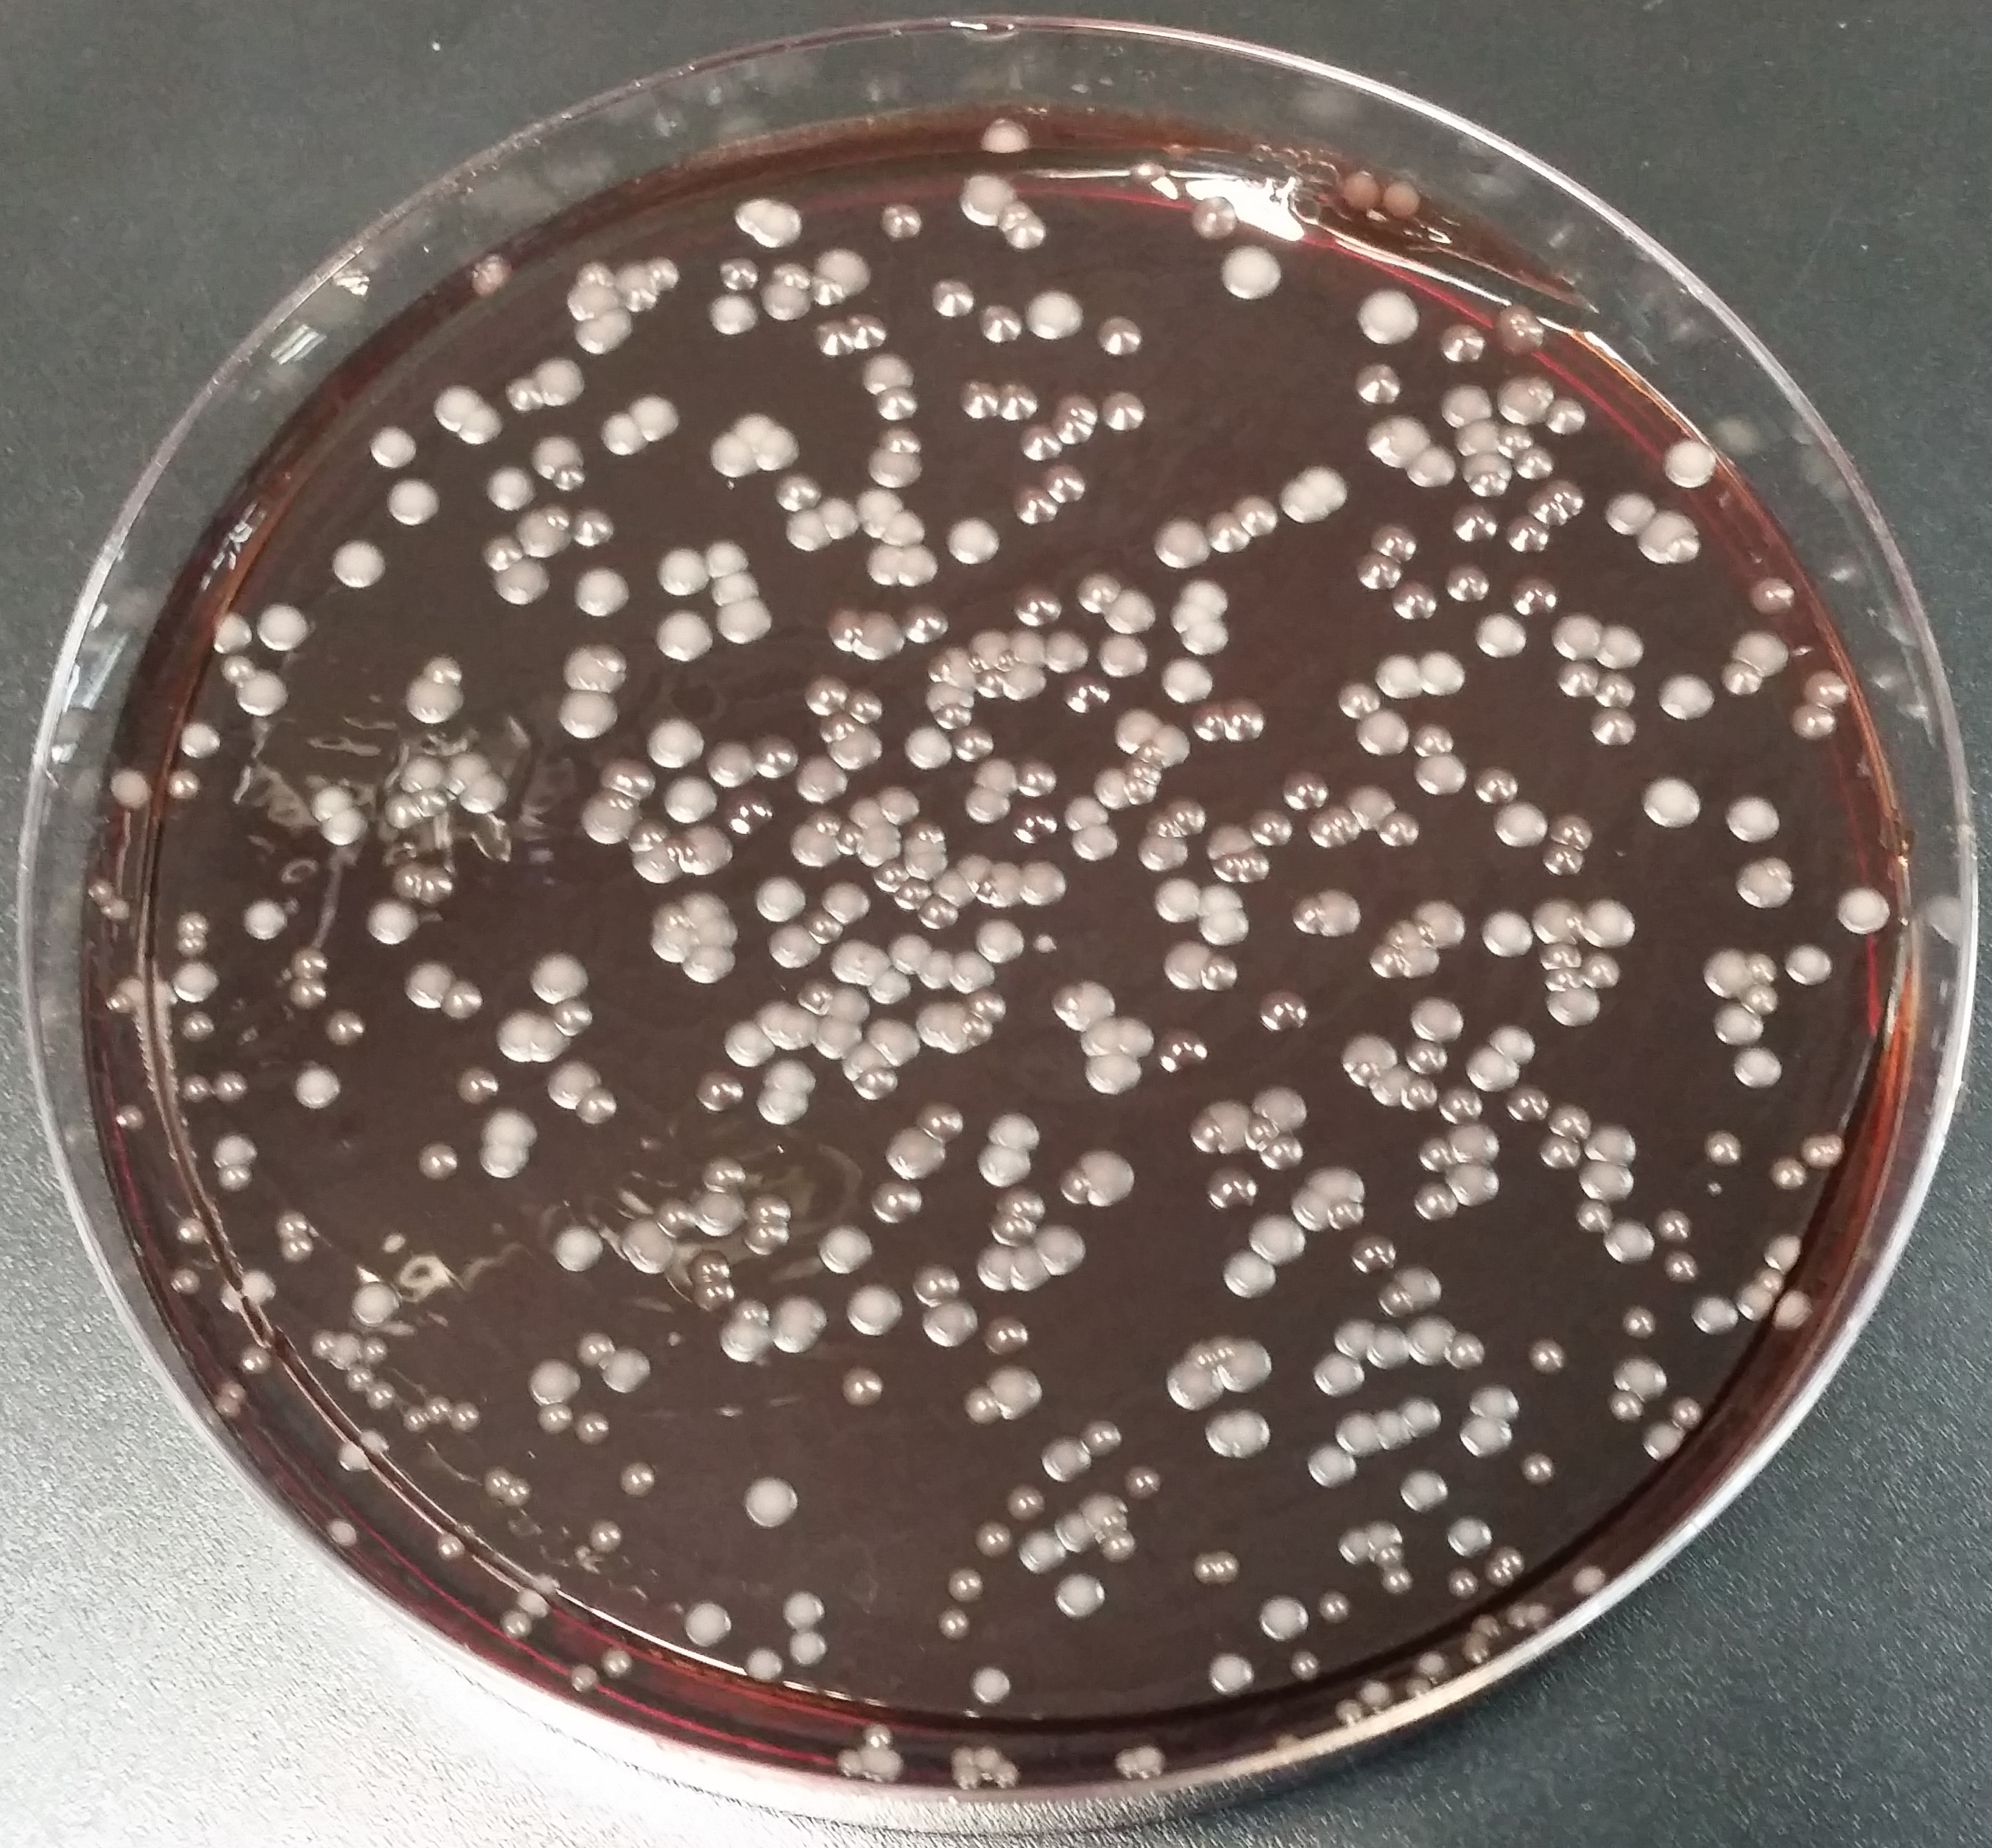

Identificación de levaduras indígenas
Reseña de tesis doctoral: Ignacio Baselga Carretero
A nivel mundial está surgiendo un mayor consumo de vinos naturales y ecológicos. Estos vinos se caracterizan por utilizar uva procedente de cultivos ecológicos, es decir, sin la aplicación de productos químicos en la vid, y por el uso de la microbiota indígena. Y desde My Scientific Journal queremos aprovechar esta creciente demanda para hablarte de las levaduras indígenas en la elaboración del vino. ¿Sabes qué es lo que busca un consumidor en el vino? Es su aroma, su color, sus notas de sabor... Lo que quizás no conozcas es que las levaduras que fermentan el caldo de uva (el mosto) son responsables no sólo de la presencia de alcohol en el vino (por un proceso bioquímico conocido como fermentación), sino de muchas de sus propiedades organolépticas.
Por ello es de gran interés estudiar las levaduras indígenas para conseguir así vinos de mayor calidad y para explicártelo nos apoyamos en la tesis doctoral del Dr. Ignacio Baselga Carretero, que se realizó en la Universidad Francisco de Vitoria (UFV) bajo la dirección del Dr. Cruz Santos Tejedor, profesor titular de Microbiología en la Universidad Francisco de Vitoria.

Dr. Ignacio Baselga Carretero
En la tesis Ignacio trabajó con 17 muestras de uva y 54 muestras de mosto fermentado de la variedad Tempranillo de Vitis vinífera. Las muestras se recogieron durante tres vendimias.
La uva Tempranillo debe su nombre a su temprana maduración, hecho que conlleva una sensibilidad mayor a las heladas primaverales. Se caracteriza por un ciclo vegetativo corto y un fruto uniforme de gruesa piel con bayas de color azul oscuro en racimos de forma cilíndrica y compactos. El mosto de uva producido por este grano es equilibrado en azúcar, color y acidez, aunque esta última suele ser reducida.

Uva tempranillo
Es cierto que a lo largo de más de 8.000 años poco ha variado el proceso biotecnológico de la fermentación del mosto de uva para la obtención de vino, si bien las circunstancias y los intereses de los consumidores a lo largo de la historia han promovido el desarrollo de pequeñas adaptaciones del proceso fermentativo. Por suerte la industria vitivinícola está volviendo a métodos de producción tradicionales con el objetivo de poner en el mercado más vinos ecológicos y naturales (Laureati and Pagliarini, 2016). Surgiendo en las últimas décadas varias técnicas moleculares que han sido ampliamente empleadas para la identificación y caracterización de levaduras vínicas. Las levaduras indígenas están presentes en el hollejo de la uva, en el mosto en fermentación y en las instalaciones de las bodegas, y su variabilidad depende de muchos factores, entre los que se encuentran las condiciones climáticas, la variedad de la uva, el tipo de terreno o el uso de fungicidas (Guzzon y col., 2014).
Debemos de tener en cuenta que son numerosos los trabajos dirigidos a la caracterización y estudio de las levaduras vínicas pertenecientes a géneros no-Saccharomyces, con el objetivo de demostrar la influencia positiva de muchas de ellas en la fermentación y desmentir la concepción que se tenía de ellas como perjudiciales (Ciani y Comitini, 2011; Cordero-Bueso y col., 2013; Garofalo y col., 2016). La existencia de un método que posibilita la identificación y caracterización de levaduras vínicas indígenas, principalmente de géneros no-Saccharomyces, y que permite una discriminación a nivel de cepa sin la necesidad de conocer el genoma de la levadura supone una ventaja, ya que a día de hoy la información genética disponible para la identificación de cepas de levadura pertenecientes a estos géneros es escasa.
En este trabajo de investigación el autor presenta un método preciso para la identificación y caracterización de levaduras y hace un análisis comparativo del aporte aromático al vino de levaduras vínicas indígenas identificadas con dicho método. Se conocen como levaduras indígenas aquellas que de manera natural están, por ejemplo, en el hollejo de la uva.
El aporte al perfil aromático del vino de estas levaduras suele estar silenciado o bloqueado por el uso de levaduras comerciales que garantizan a la bodega una producción constante en cada vendimia. Si bien, un cambio en el interés del consumidor de un tiempo a esta parte parece apuntar a la búsqueda de vinos más auténticos, como los clasificados como vinos de autor, que, entre otras características, buscas el empleo de la levadura autóctona de las viñas como símbolo de identidad.

Después de analizar el trabajo realizado por el Dr. Ignacio Baselga Carretero nos gustaría comentar que sigue una estructura coherente, un análisis profundo y detallado, y presenta una cierta relevancia industrial, pero tanto el análisis de sus datos de manera ¨manual¨, como en el caso de los perfiles AFLP, o la ausencia de programas de código como R, podrían dar lugar a una interpretación errónea de tener en las manos un estudio obsoleto. Ya que consideremos interesante el empleo de técnicas como la secuenciación masiva de los perfiles AFLP generados que darían una información complementaría de extremada significancia. Antes de despedirnos nos gustaría remarcar que, es un trabajo patentado que resultó en la producción de un vino único. Lo que le granjea una relevancia remarcable.
Documentación y Reseña

Alba Peña Hidalgo
Redactora My Scientific